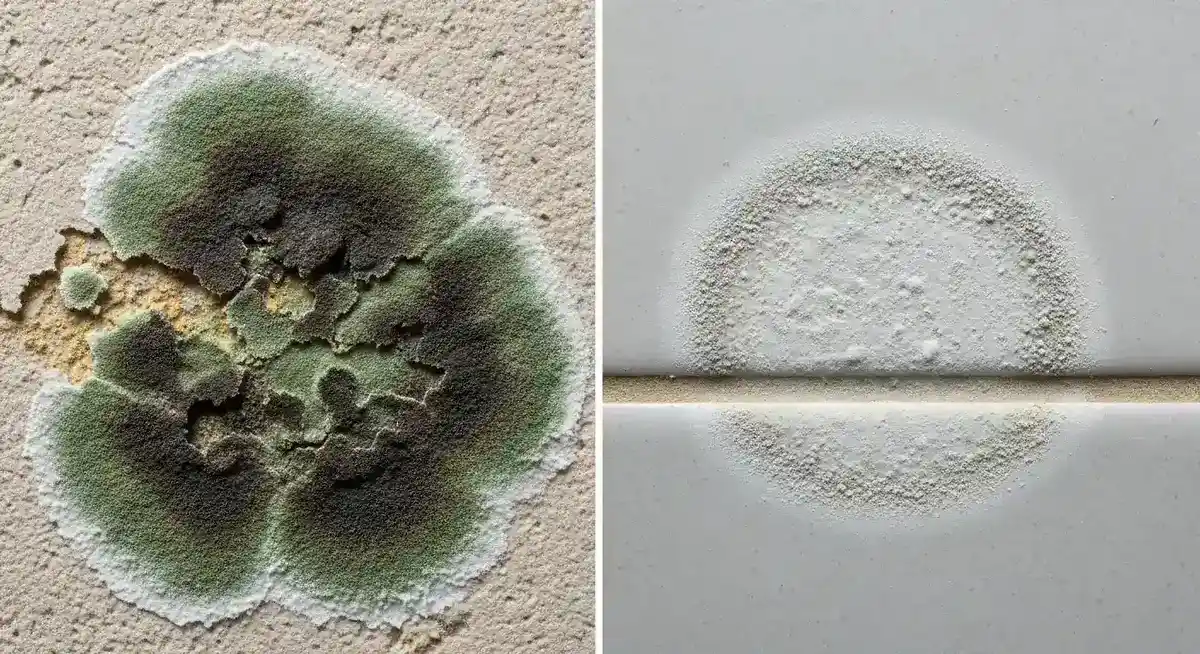
Side-by-side comparison showing dark fuzzy mold growth versus flat powdery mildew on household surfaces

Mold Identification: 8 Types, Color Chart & Photos (2026)
Identify 8 common household molds by color, texture, and location. Mold identification chart, photo guide, and what looks like mold but isn't.
You spotted something fuzzy. It's on a wall, behind the sink, or along the bathroom ceiling, and now you're trying to figure out what it is before you decide what to do about it.
Good news: most mold you'll find in a house is ordinary and something you can handle yourself. Bad news: a small number of types are serious and shouldn't be touched without the right gear. This guide covers both, with photos, a color chart, and a section on the half-dozen things that look like mold but aren't.
In This Guide
- What is Mold?: how mold grows and spreads
- Common Types: 8 types including black, green, white, and more
- Mold Identification Chart: quick-reference comparison table
- Mold vs mildew (quick summary): the short version, plus the full breakdown
- What Looks Like Mold But Isn't: common lookalikes
- Where Mold Grows: high-risk and hidden locations
- Health Risks: symptoms and who's at risk
- When to Call a Pro: professional assessment guide
- How to Identify Mold: visual, bleach test, and smell test

What is Mold?
Mold is fungus. It's outside right now, on every fallen leaf and piece of dead wood within a hundred feet of you, and that's supposed to be there; that's its job. The problem starts when it finds its way inside, lands on something damp, and stays.
How Mold Spreads
Mold makes spores, which are small enough that you're breathing some in at this exact moment. Nothing to panic about; they're in the air everywhere, indoors and out. They only turn into a visible mold patch when they land somewhere wet and don't get dried out fast enough.
What Mold Needs to Grow
Mold needs four things. Take away any one of them and it can't grow.
Moisture. This is the one that matters. If your house is genuinely dry, you don't have a mold problem. Full stop.
Something to eat. Drywall, wood, paper, fabric, even the dust on the back of your TV. If you've got a house, you've got mold food.
A comfortable temperature. 60 to 80°F. The same range you're sleeping in.
Stagnant air. Basements, crawlspaces, that corner of the closet you never open, behind the couch that's been pushed against an exterior wall since you moved in.
Common Types of Household Mold

Color and texture tell you a lot before anyone takes a sample. Here's what the most common household molds actually look like, and where they tend to show up.
Black Mold (Stachybotrys chartarum)

This is the one people mean when they say "toxic black mold." Stachybotrys chartarum is the most concerning mold you're likely to find in a house, and it's the one you shouldn't try to clean yourself.
Warning: If you think you're looking at black mold, don't poke it, don't try to wipe it, and don't run a fan anywhere near it. All three aerosolize the spores. Call a mold assessor. That's the professional who tests, not treats, and they'll confirm what it actually is.
Black mold reads as dark greenish-black, slimy when it is actively growing and powdery when it dries, and it takes hold on cellulose like drywall, ceiling tiles, and wood that has stayed wet for days. Color alone cannot confirm the species, so treat any black patch as worth taking seriously and confirm with a test rather than by sight.
For the full visual breakdown, including what black mold actually looks like, surface by surface and how to tell it apart from soot, water stains, and other look-alikes, see the dedicated appearance guide.
Green Mold (Aspergillus and Penicillium)

"Green mold" is usually Aspergillus or Penicillium. These are two of the most common indoor molds, and two of the species you've almost certainly encountered already (Penicillium is the mold that gives us blue cheese and penicillin).
Appearance:
- Ranges from light green to dark olive green
- Can appear blue-green or yellow-green
- Usually has a powdery or fuzzy texture
- May have white edges where actively growing
Where it grows:
- On food items (bread, fruits, vegetables)
- Air conditioning systems and ductwork. More on this in our complete mold removal guide.
- Walls and insulation
- Fabrics and carpets
- Wallpaper and painted surfaces
Key characteristic: Spreads fast and covers large areas quickly. Most strains are relatively harmless, but some trigger allergic reactions or respiratory issues, especially in anyone with asthma or seasonal allergies.
White Mold

"White mold" isn't a single species. It's either a mold that happens to stay white throughout its lifecycle, or a mold that will eventually turn green, gray, or black once it matures. Either way, finding it early is useful; it's usually the first visible sign you've got a moisture problem.
Appearance:
- White or light gray color
- Powdery or fluffy texture
- Can be mistaken for efflorescence (mineral deposits) on concrete
- May have a subtle musty smell
Where it grows:
- Basement walls and floors
- Attics and crawl spaces
- Around wood framing
- On furniture
- In closets with poor ventilation
Key characteristic: Shows up in high-humidity areas even when there's no visible leak. If you see white mold on basement wood framing, something is keeping that wood damp, even if you can't figure out what.
Pink Mold (Aureobasidium pullulans and Serratia marcescens)

The pink ring in your shower isn't technically mold. Most of the time it's Serratia marcescens, a bacteria that thrives on soap scum and stays wet in the steam coming off your showerhead. It looks like mold, acts like mold, and is treated like mold, so people call it pink mold and move on.
Appearance:
- Pink, orange, or reddish color
- Slimy texture
- Often appears in circular or spot patterns
- May darken to brown or black as it ages
Where it grows:
- Bathroom tiles and grout
- Shower curtains and liners
- Around faucets and drains
- On shampoo bottles and soap dishes
- Window sills in humid rooms
Key characteristic: Lives on soap residue and standing water. Not as serious as black mold, but for anyone with a compromised immune system, it can cause real respiratory issues and infections. Don't ignore it because it looks harmless.
Cladosporium

Cladosporium is the mold you probably already have somewhere. It's one of the most common molds in the world, indoors and out, and it has one trick that sets it apart: it can grow in cool temperatures when most other molds can't. That's why you sometimes find it inside refrigerators.
Appearance:
- Olive-green to brown or black color
- Suede-like or velvety texture
- Grows in clusters of small spots that expand outward
- Can appear on both sides of surfaces
Where it grows:
- Window sills and frames
- Bathroom ceilings and walls
- HVAC ducts and air filters
- Fabrics, carpets, and upholstery
- Under sinks and around plumbing
Key characteristic: Grows in cold conditions where most molds can't. Also one of the top triggers for hay fever and asthma flare-ups. If allergy season feels worse inside your house, Cladosporium is a likely suspect.
Alternaria

Alternaria is the mold most responsible for allergic reactions in homes. It rides in on open windows, clothes, and pets, then settles in wherever it finds damp, usually around windows with condensation or on walls after a leak.
Appearance:
- Dark brown to dark green or gray
- Velvety texture with hair-like filaments
- Grows in large, spreading colonies
- Often has a distinctive fuzzy border
Where it grows:
- Showers, bathtubs, and below leaking sinks
- Around window frames with condensation
- In kitchens near sinks and dishwashers
- On walls and ceilings after water damage
- In air conditioning systems
Key characteristic: Fast. It can colonize a damp surface in a few days. Strongly tied to allergic reactions and asthma attacks, and children tend to react to it harder than adults.
Chaetomium

Chaetomium is the mold that tells you something is leaking, even if you haven't found the leak yet. If you see it, don't just treat the mold; find the water source, because the mold will come right back until you do.
Appearance:
- Starts white or gray, darkens to olive green or brown over time
- Cottony or fuzzy texture
- Produces a strong, distinctive musty odor
- Often found alongside other molds like Stachybotrys
Where it grows:
- Drywall and wallboard that has been water-damaged
- Roof leaks and around skylights
- Basement walls after flooding
- Around plumbing leaks inside wall cavities
- On wet cardboard and paper products
Key characteristic: Smells strong enough that you often notice it before you see it. That distinctive musty odor is frequently how people first realize they have a hidden water problem.
Mucor

Mucor looks almost like a pile of wet cotton balls. It forms thick, fluffy patches that can cover a lot of ground fast, especially near HVAC vents and anywhere condensation pools. Homes with inconsistent climate control are where it shows up most.
Appearance:
- White or grayish, can turn yellow-brown with age
- Thick, fluffy, cotton-like texture
- Grows in large patches rather than small spots
- Can appear almost pillow-like when mature
Where it grows:
- Near HVAC systems and air ducts
- On carpet and carpet padding
- In condensation-prone areas (near windows, uninsulated walls)
- Around old or decaying organic materials
- In soil of overwatered houseplants
Key characteristic: Grows fast in warm, humid conditions. In rare cases it causes mucormycosis, a serious infection that mainly affects people with weakened immune systems. For most households it's a nuisance, not an emergency; for anyone immunocompromised, it's something to take seriously.
Orange and Yellow Mold

Bright orange or yellow growth indoors is less common than black or green, and it isn't always a true mold. Some of what looks orange in a crawl space is actually slime mold, which is a different organism entirely. Either way, it's a moisture problem that's gone on long enough to be visible, which means it's worth addressing.
Appearance:
- Bright orange, yellow, or yellowish-green
- Can be slimy (like slime mold) or powdery
- Sometimes appears as a bright, crusty growth
- Slime mold may look wet or gelatinous
Where it grows:
- On wooden surfaces, especially in crawl spaces and basements
- Around bathroom fixtures and tiles
- On food items and in refrigerators
- On mulch and garden materials near entry points
- In HVAC condensation pans
Key characteristic: If it's slime mold (Fuligo septica), it's technically not mold. It's a slime-forming protist that behaves like mold. Doesn't really matter for you as a homeowner. Treat it the same way: find the water, dry it out, remove the growth.
Brown and Gray Mold
Most of the time, brown or gray mold isn't a separate species at all; it's one of the molds above in a different life stage. Mold changes color as it matures. A colony that started white might turn green, then brown, then black over a few weeks.
Appearance:
- Light tan to dark brown, or silvery gray
- Texture varies. Can be powdery, velvety, or slimy.
- Often irregular or patchy patterns
- May look like a dark stain or water damage
Key characteristic: Treat brown or gray patches the same as any other mold. Find the moisture source first, then deal with the growth. Color by itself doesn't tell you much.
Mold Identification Chart
If you've got a spot and want to narrow it down fast, match what you're seeing against the table below.
| Mold Type | Color | Texture | Common Locations | Risk Level |
|---|---|---|---|---|
| Black mold (Stachybotrys) | Dark greenish-black | Slimy when wet, powdery when dry | Chronically wet drywall, ceiling tiles, behind wallpaper | High; call a pro |
| Green mold (Aspergillus/Penicillium) | Light to dark green, blue-green | Powdery or fuzzy | Food, HVAC systems, walls, carpets | Moderate; can cause allergic reactions |
| White mold | White to light gray | Powdery or fluffy | Basements, attics, crawl spaces, wood framing | Moderate; early sign of moisture problems |
| Pink mold (Aureobasidium/Serratia) | Pink, orange, reddish | Slimy | Bathroom tiles, grout, shower curtains, drains | Low to moderate; infections in immunocompromised |
| Cladosporium | Olive-green to brown or black | Velvety or suede-like | Window sills, HVAC ducts, fabrics, bathroom ceilings | Moderate; common allergen and asthma trigger |
| Alternaria | Dark brown to dark green | Velvety with hair-like filaments | Showers, sinks, window frames, after water damage | Moderate to high; strong allergen, fast grower |
| Chaetomium | White to olive green (darkens with age) | Cottony or fuzzy | Water-damaged drywall, roof leaks, basement walls | Moderate; strong sign of water damage |
| Mucor | White to grayish, yellows with age | Thick, fluffy, cotton-like | HVAC systems, carpet, condensation areas | Moderate to high; can cause mucormycosis in immunocompromised |
One note: Color alone isn't a reliable way to pin down the exact species. Molds shift colors as they age, and the only way to know for sure is lab testing. When you need certainty, get a professional mold assessment.
Mold vs Mildew (Quick Summary)

People use "mold" and "mildew" interchangeably, but they aren't quite the same. Both are fungi, and mildew is really a flat, surface-level form of mold: white or gray, powdery, and easy to wipe off a hard surface. What people call mold is the fuzzy, raised growth that roots into drywall, wood, and ceilings and usually needs more than a wipe.
The shortcut: mildew sits on top. Mold goes in. If it's raised, fuzzy, or dark, treat it as mold. You can always downgrade your concern later if it turns out to be mildew, but it's harder to undo the other direction.
For the side-by-side table on color, texture, smell, and health risk, plus a simple at-home test and surface-by-surface guidance, see the full mold vs mildew breakdown.
What Looks Like Mold But Isn't
Before you start pulling off drywall, check whether you're actually looking at mold. A handful of ordinary household things get mistaken for it all the time.
- Efflorescence. White, powdery deposits on concrete, brick, or stone walls. These are mineral salts left behind when water evaporates through masonry. Unlike mold, efflorescence dissolves in water and won't return once the moisture source is fixed.
- Dirt and soot buildup. Dark accumulations near air vents, windows, or high-traffic areas. Dirt feels gritty and doesn't have a fuzzy or slimy texture.
- Soap scum. White or grayish film on bathroom surfaces. It wipes away easily and doesn't have a musty smell.
- Water stains. Brown or yellowish rings on ceilings or walls from past leaks. These are flat discolorations, not raised growth. A water stain can point to a moisture problem that will lead to mold if you don't address it.
- Iron bacteria. Orange or rust-colored stains near drains, toilets, or water fixtures. Caused by iron-oxidizing bacteria in the water supply, not mold.
- Pollen accumulation. Fine yellowish-green powder on windowsills and outdoor surfaces during allergy season. Wipes away easily and doesn't come back unless more pollen lands.
How to Tell the Difference
The bleach test is the fastest way to rule things in or out. Dab a drop of household bleach on the suspicious spot. If it lightens within one or two minutes, you're looking at mold or mildew. Dirt, efflorescence, and mineral deposits won't change color.
Other signs it's mold and not a lookalike:
- Fuzzy, slimy, or raised texture
- Musty or earthy smell in the area
- The discoloration keeps coming back after you clean it
- The spot has a history of moisture problems or past water damage
When the bleach test is inconclusive and the smell test isn't giving you much, a professional mold assessor can take samples and give you a definitive answer.
Where Mold Commonly Grows
If you're trying to track down where mold is likely to be hiding, start with the places that stay damp the longest.
High-Risk Areas
- Bathrooms. Near showers, tubs, toilets, and under sinks. Bathroom mold guide →
- Kitchens. Under sinks, around refrigerators, and near dishwashers.
- Basements. On walls, floors, and around foundation cracks. Basement mold guide →
- Attics. Near roof leaks, around vents, on insulation. Attic mold guide →
- Laundry rooms. Behind washers and around dryer vents.
- Crawl spaces. On floor joists, vapor barriers, and supports. Crawl space mold guide →
Hidden Locations
A lot of mold grows where you can't see it:
- Behind drywall and wallpaper
- Inside HVAC ducts and systems
- Under carpeting and padding
- Behind cabinets and furniture
- Inside wall cavities around plumbing
- Beneath flooring materials
Signs of Hidden Mold
You can't see it, but these are the signs it's there:
- Persistent musty or earthy odors
- Visible water stains on walls or ceilings
- Peeling or bubbling paint or wallpaper
- Warped or buckled flooring
- Chronic allergy symptoms that improve when away from home
Health Risks Associated with Mold
How mold affects you depends on three things: how sensitive you are, how much exposure you've had, and which mold it is. For a fuller breakdown of symptoms by mold type, short-term vs. long-term effects, and when a doctor visit is warranted, see our mold exposure symptoms guide.
Common Symptoms of Mold Exposure
Most people get mild symptoms:
- Nasal congestion and runny nose
- Sneezing
- Eye irritation (redness, itching, watering)
- Skin rashes or irritation
- Throat irritation
- Coughing
- Headaches
More Serious Reactions
Some people get hit harder:
- Difficulty breathing or shortness of breath
- Fever
- Chronic fatigue
- Memory problems or difficulty concentrating
- Persistent sinus infections
If you're in a high-risk group (compromised immune system, chronic respiratory condition, severe allergies, or asthma), you're at significantly higher risk from mold exposure. Don't try to handle anything beyond a small patch yourself, and see a doctor if symptoms develop.
When to Call a Professional
A patch under 10 square feet is usually something you can handle yourself. Bigger than that, or in the situations below, you need a pro. Not sure which side of the line you're on? DIY vs. professional removal →
Call a Professional Immediately If:
- The affected area exceeds 10 square feet - Larger infestations require professional containment and removal
- You suspect black mold - The health risks are too significant for DIY remediation
- Mold is in your HVAC system - Can spread spores throughout your entire home
- You've had sewage backup or contaminated water - Creates additional health hazards
- The mold keeps returning - Indicates an unresolved moisture problem
- You or family members have health symptoms - Especially respiratory issues
- You can smell mold but can't find it - Hidden mold requires professional detection
When you're not sure, call someone. A professional mold assessment is affordable and it's a lot cheaper than the health or property damage that comes from guessing wrong.
What a Professional Assessment Actually Involves
A certified mold assessor will:
- Conduct a thorough visual inspection
- Use moisture meters to detect hidden water issues
- Collect air and/or surface samples if needed
- Identify the moisture source causing the problem
- Provide a detailed report with remediation recommendations
Choosing the Right Professional
Here's what to look for:
- State licensing (required for mold assessors in many states)
- Current insurance coverage
- Verifiable certifications from recognized organizations like IICRC
- Detailed written assessments, not just verbal opinions
- No conflict of interest. The assessor shouldn't also be doing the remediation (here's why that matters)
For the full process, see our hiring guide, along with questions to ask and scams to avoid.
How to Identify Mold in Your House
Mold identification comes down to three things: what it looks like, where it's growing, and whether it passes a simple test.
Visual clues:
- Fuzzy or slimy texture. Mold is raised from the surface; dirt and stains lie flat.
- Irregular patches. Mold spreads outward from a moisture source in organic, splotchy patterns.
- Color. Green, black, white, brown, orange, or gray. Use the chart above to narrow it down.
- Growth pattern. Mold follows water. If the discoloration is clustered around pipes, windows, HVAC vents, or old water stains, you're probably looking at mold.
The bleach test. Dab a drop of household bleach on the spot. If it lightens within 1–2 minutes, it's mold or mildew. Dirt and mineral deposits won't change color.
The smell test. Mold has a distinctive musty, earthy odor. If a room smells damp even after you've cleaned it, there's probably hidden mold behind a wall, under flooring, or in a ceiling cavity.
When you still can't tell. A professional mold assessor has moisture meters, thermal imaging, and air sampling that can confirm what's there and what species it is. That's when it's time to bring one in.
Next Steps
If you're pretty sure you've got mold, here's the order of operations:
- Document what you see. Photos and measurements of the affected area.
- Find and fix the moisture source. Mold can't survive without water. If you don't fix the leak, nothing else matters.
- Don't disturb it. Poking, wiping, or fanning mold aerosolizes the spores.
- Measure the patch. Under or over 10 square feet?
- Decide your approach. DIY for small patches of common mold. Professional for anything larger, any suspected black mold, or anything in an HVAC system.
Find a Verified Mold Professional
Your home and your health are both on the line, so don't hire the first name that shows up. Find a verified mold inspection company in your area. Every professional we list has been vetted for proper licensing, insurance, and reputation.
📚 This guide is part of our Complete Mold Remediation Guide. Your full resource for understanding, preventing, and removing mold.
Frequently Asked Questions
What does mold look like on walls?
How can you tell the difference between mold and mildew?
Is all black mold toxic?
Can mold be hidden behind walls?
What does mold smell like?
How quickly should you address mold in your home?
What does early stage mold look like?
How can you tell if it's mold or dirt?
Can mold grow on concrete?
What color mold is the most dangerous?
If what you found needs a pro, you can browse verified mold remediation companies — every contractor is license-checked, insurance-checked, and reviewed.
This guide is for educational purposes only. Always consult with certified professionals for specific mold situations in your home. If you experience health symptoms, please consult a healthcare provider.